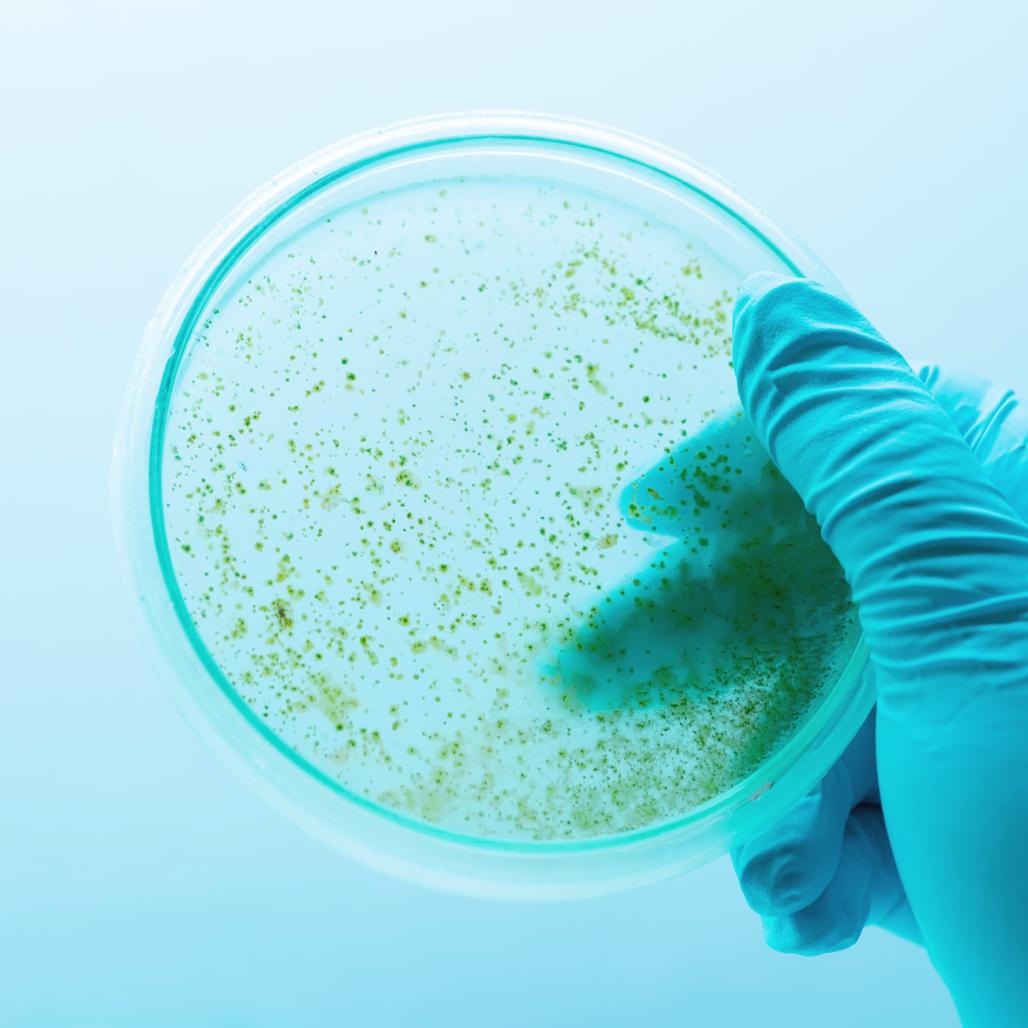

Laboratory automation is the integration of automated technologies into the laboratory to enable new and improved processes.
Typically, lab automation solutions eliminate the most repetitive tasks in a lab, such as library preparation or liquid handling, that have typically been performed manually by lab technicians or scientists. However, as the technology advances, more and more complex processes, and even whole workflows, can be automated. And, increasingly, automated technology is a requirement in today’s laboratories to remain competitive and meet demand.
Today’s busy laboratories face increasing pressures to improve both throughput, efficiency and quality, while their resources and manpower are often stretched to the absolute limit. The need to manage complex tests, multiple workflows and time-consuming sample preparation presents significant challenges to labs of all shapes, sizes and specialities.
As a result, many labs utilise laboratory automation to replace manual, repetitive tasks, increase throughput and improve quality. Whether a single piece of equipment, such as a pipette machine or automatic aliquoting machine, or a full workflow automation, lab automation can be a gamechanger for these labs.

The benefits of lab automation
The main lab automation benefits are reproducibility (quality), data accuracy, traceability, efficiency, safety, and faster translation from bench to bedside.
Reproducibility
Reproducibility has always been a major concern for laboratories. In 2011, a Nature survey highlighted the widespread challenge of reproducibility when it found that 70% of scientists have tried and failed to reproduce another’s experiments.
Automation has the potential to reduce handler-induced variability and contamination, resulting in improvements in quality of results.
In the research environment, for example, laboratory automation can enable a greater rate of experimental data capture, increased volume of results, and the use of a wider range of controls, increasing the likelihood that results will be reproducible. Reproducible data can then be built upon with further research.
Elsewhere, in clinical labs, automation can also reduce pre-analytic errors such as mislabelling or misplacing samples, or selecting the wrong media.
Data accuracy
Data accuracy is one of the aspects of laboratories that can be improved with lab automation. In the microbiology lab, consistent automated plate streaking of urine samples allows for more accurate differentiation of a potential pathogen from contaminating microbiota, for instance.
Automated processes and tools can incorporate machine learning algorithms that improve the accuracy of data evaluation compared to human-based interpretation. They do this by avoiding idealised training subsets and learning from a larger pool of real samples. For example, automation of slide imaging and Gram stain interpretation can improve upon the manual classification of common bloodstream pathogens, and automated echocardiogram analysis can classify a range of pathologies with high levels of accuracy.
Traceability
Traceability is another significant benefit of lab automation.
The ability to compare test results to each other and to standards is critical both to academic research laboratories and clinical laboratories. Another important aspect of traceability is data provenance, the ability to describe the history and origins of data.
In the research lab, traceability is essential to enable the translation of findings to the clinic. In the clinical laboratory, on the other hand, the importance of this concept is highlighted by the inclusion of metrological traceability in the requirements for accreditation by ISO 15189:2012. In cases where clinical practice guidelines recommend medical action based on test results, traceability mitigates the risk of medical harm to a patient.
The challenges inherent in maintaining traceability in any life sciences laboratory can be eliminated with automation. Laboratory automation increases the capacity of the lab to process samples with adequate documentation and accuracy, and it can also take care of the chain of custody of data.

Efficiency
In laboratories of all shapes and sizes, automated machinery can improve the efficiency of lab workers by achieving a greater rate of output than manual alternatives. This means that time saved on repetitive tasks can be spent on research, planning or running other protocols.
Studies have shown that clinical lab automation is associated with a reduction in turnaround time. Therefore, lab automation allows technicians to devote more time to more skilled tasks that they have spent years training for, such as plate reading and interpretation, rather than repetitive tasks.
Lab automation can also increase efficiency by reducing the volumes of reagents/media used, through a higher level of dispensing precision.
Laboratory workflow automation can also enable an extension in laboratory opening hours. For example, in the microbiology lab, automatic plating systems can process specimens and inoculate plates 24 hours per day.
Safety
In some labs, protocols exist that require the handling of dangerous chemicals and machinery. Automation of these protocols can reduce the safety risk to researchers and technicians.
Increased lab automation also reduces the risk of contamination of laboratory surfaces with infectious biological samples, and the risk of repetitive strain injury in laboratory staff.
Faster translation
Including automation in the research process can reduce the time it takes to translate results from ‘bench to bedside’. The technological leap from the laboratory to commercialisation and deployment in the clinic is shorter if aspects of the process have already been mechanised.
Which lab processes can be automated?
The same tasks that are most prone to human error are often those that are most suitable for automation – the repetitive, monotonous laboratory tasks. For example, centrifugation, de-capping, recapping, aliquoting, sorting, or colony counting.
In addition, total lab automation solutions can also include sophisticated process control software, conveyor transportation or laboratory robotics, interfaces to analysis machinery, and even sample storage and retrieval systems.

Lab Automation and data integration
Many labs today incorporate a LIMS, to keep track of data associated with experiments, instrumentation, samples, and laboratory workflows. The integration of LIMS data with automated machinery and processes offers the potential for lab automation systems to improve workflow through machine learning and artificial intelligence.
For example, in the microbiology lab, machine learning coupled with digital imaging can be used to train image analysis software to screen for bacterial cultures in water samples. In practical terms, introducing lab automation using LIMS data can increase efficiency by allowing technologists to focus their time on the analysis of results, rather than spending hours manually counting colonies.
What is the difference between partial automation and laboratory workflow automation?
Most labs implementing automation today adopt an approach of partial automation. This is where they buy a single piece – of several pieces – of automated equipment, such as a liquid handler.
Partial automation removes the repetitive tasks involved with a particular process in the lab, however the machine still has to be operated by a lab worker and many in-between steps, such as barcode scanning, have to be done manually. Ultimately, the benefits of automating just one small part of the assay are limited.
Laboratory workflow automation, on the other hand, links multiple processes and workflows in order to automate entire assays. Laboratory workflow automation normally encompasses both lab automation hardware and lab automation software to form an integrated system that automates the whole workflow.
What is modular lab automation?
Modular lab automation solutions combine laboratory robotics and automation in a modular fashion, allowing labs to adapt to different workflows. These solutions can be easily taken apart and put back together, or easily altered. Modular automation systems can be connected by a track system or lab automation robots, and even de-capping, centrifugation, and aliquoting may be automated.
Modular automation provides the flexibility for customers to cost-justify the functions they want to include. In the past, lab automation solutions were so bulky, complex and expensive that only the largest labs could access them. However, the increasing availability of modular automation solutions provided by lab automation companies means that, today, laboratory automation solutions are far more accessible and can be designed to meet the needs of both large and small laboratories.

Summary
Laboratory automation has seen substantial growth in the last few decades, with an increasing range of automated functions and modular options in the lab automation market. Although the initial driver may have been cost savings, opportunities to reduce turnaround time and increase reproducibility, quality, and safety are becoming increasingly apparent.
As a result, the demand and capacity for automation in labs of all shapes and sizes is on the increase.
Learn more about Automata’s lab automation platform, LINQ, today.